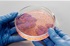

Hrvatice otkrile trik: Popijemo ovo ujutro i salo se topi samo do sebe
Foto: Ilustracija/Pexels
Zaboravite skupe dijete, tablete i neukusne shakeove – žene diljem Hrvatske kunu se u ovaj jednostavni napitak koji pripremaju kod kuće, a rezultati su vidljivi već nakon nekoliko dana!
U moru savjeta o mršavljenju, jedan trik posebno se istaknuo među ženama koje žele izgubiti kilograme na prirodan i zdrav način. Ne, nije riječ o nikakvom čudu iz ljekarne – sve što vam treba već imate kod kuće.
Tajna je u jutarnjoj rutini
Svakog jutra, prije doručka, popiju napitak od mlake vode, limuna, jabučnog octa, meda i prstohvata cimeta. Recept je jednostavan, priprema traje manje od minute, a tijelo odmah reagira.
Recept:
1 šalica mlake vode
Sok pola limuna
1 čajna žličica jabučnog octa
Prstohvat cimeta
(Po želji: 1 čajna žličica meda)
Sve sastojke dobro promiješajte u čaši mlake vode i popijte natašte, odmah nakon buđenja.
Zašto djeluje?
Limun potiče detoksikaciju jetre i ubrzava probavu
Jabučni ocat dokazano stabilizira razinu šećera u krvi i pomaže sagorijevanju masnoća
Cimet kontrolira apetit i sprječava nagle napade gladi
Med dodaje prirodnu slatkoću i djeluje protuupalno
Brojne žene tvrde da su već nakon tjedan dana osjetile manje nadutosti, više energije i – najvažnije – lakše su zakopčale omiljene traperice.
Nema magije – samo priroda
Ovaj napitak nije čarobni štapić, ali u kombinaciji s malo kretanja i umjerenom prehranom može biti snažan saveznik u borbi protiv kilograma. I što je najbolje – nema kemije, nema nuspojava i ne košta gotovo ništa.
Probajte već sutra ujutro i pridružite se tisućama žena koje su ovaj trik već uvrstile u svoju jutarnju rutinu. Rezultati bi vas mogli iznenaditi!
 Prethodni članak
Prethodni članak
 Sljedeći članak
Sljedeći članak








![[FOTO] I Zagorci su uz Vatrene: Dvadesetak navijača otputovalo na utakmicu Hrvatske i Portugala](/Resource/SmartSize?url=~%2FCms_Data%2FContents%2Fzagorjecom%2FFolders%2FSlike%2F~contents%2FZM62BSHSW283BWTW%2Fbefunky-collage---2026-07-02t221626.845.jpg&width=80&height=80&vAlign=center&hAlign=center)
 Vuk noćas ušao u dvorište u Zagorju? 'Uspjela sam ga snimiti bljeskalicom'
Vuk noćas ušao u dvorište u Zagorju? 'Uspjela sam ga snimiti bljeskalicom'
 Gotovo svi pogriješe čim donesu lubenicu kući, a zbog toga izgubi slatkoću
Gotovo svi pogriješe čim donesu lubenicu kući, a zbog toga izgubi slatkoću
 Jednostavno i pristupačno: Riješite se crnih mrlja na ružama uz jednu namirnicu iz hladnjaka
Jednostavno i pristupačno: Riješite se crnih mrlja na ružama uz jednu namirnicu iz hladnjaka
 Nesvakidašnja krađa u Zagorju: Ženi iz vrta ukrali 200 kg krumpira
Nesvakidašnja krađa u Zagorju: Ženi iz vrta ukrali 200 kg krumpira
 Foto s mjesta stravične nesreće: Sudarili se automobili, Hitna pomoć i vatrogasci na terenu - Sve je puno stakla
Foto s mjesta stravične nesreće: Sudarili se automobili, Hitna pomoć i vatrogasci na terenu - Sve je puno stakla
 Tragična nesreća: Motocikl sletio s ceste, jedna osoba poginula
Tragična nesreća: Motocikl sletio s ceste, jedna osoba poginula
 [PROGNOZA VREMENA] Evo kada su mogući pljuskovi
[PROGNOZA VREMENA] Evo kada su mogući pljuskovi
 Drama na moru zbog bure. Požar jedrilice, bura na dasci odnijela malu djecu...
Drama na moru zbog bure. Požar jedrilice, bura na dasci odnijela malu djecu...
 FOTOGALERIJA: Bračni portreti iz Marije Bistrice
FOTOGALERIJA: Bračni portreti iz Marije Bistrice
 Vikend pred nama: Sunce, smijeh i neočekivane prilike!
Vikend pred nama: Sunce, smijeh i neočekivane prilike!
 Monitoring bijele rode 2026.
Monitoring bijele rode 2026.
 Aplikacija iNaturalist – istraži i podijeli svoja opažanja iz svijeta prirode
Aplikacija iNaturalist – istraži i podijeli svoja opažanja iz svijeta prirode
 Prirodan izgled novi je beauty imperativ: Sve više Zagorki bira suptilne estetske tretmane
Prirodan izgled novi je beauty imperativ: Sve više Zagorki bira suptilne estetske tretmane
 Održana 11. Noć noćnih leptira
Održana 11. Noć noćnih leptira
[VIDEO] Zašto pacijenti sve češće biraju EsteticaDent, jedan od najmodernijih dentalnih centara u Zagorju
[VIDEO] Zašto pacijenti sve češće biraju EsteticaDent, jedan od najmodernijih dentalnih centara u Zagorju
